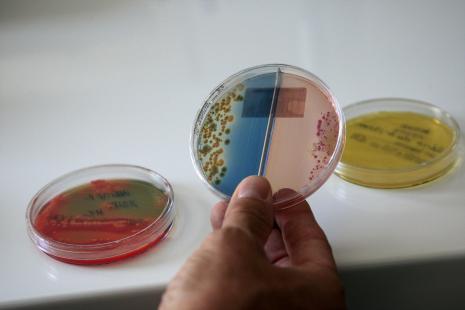
L'hémophilus est de plus en plus résistant aux antibiotiques

Le Quotidien du Pharmacien.- Quels sont les germes qui présentent le plus de résistance en ce qui concerne les infections ORL de l’enfant ?
Dr Martine François.- L’Hémophilus est un germe de plus en plus résistant, mais nous disposons d’antibiotiques d’administration aisée, bien tolérés et qui demeurent efficaces. En outre, nous avons à notre disposition un vaccin évitant les infections graves pouvant être causées par ce germe, que sont les épiglottites, les méningites et les arthrites.
Les streptocoques pyogènes du groupe A développent également des résistances ; quant à ceux du groupe B, ils concernent essentiellement les nouveau-nés.
Le problème le plus préoccupant est représenté par le pneumocoque, à l’origine d’un très grand nombre d’otites moyennes aiguës, mais aussi d’infections invasives graves, pneumopathies et méningites.
Or, le niveau de résistance de cette bactérie est particulièrement élevé. C’est ainsi qu’il y a une dizaine d’années, près de 70 % des pneumocoques responsables d’otites récidivantes avaient une sensibilité diminuée à la pénicilline ! Les choses se sont un peu améliorées depuis le lancement de campagnes de bon usage, mais il ne faut pas relâcher les efforts en ce domaine.
Dans quel contexte le problème se pose-t-il ?
Il est essentiel d’avoir présent à l’esprit que les angines et les otites se développent à partir des germes initialement saprophytes que nous hébergeons à la surface de nos muqueuses. Sans qu’on connaisse précisément les raisons de ce mécanisme. Et qu’une antibiothérapie intempestive, par exemple dans le cadre d’une infection virale, ou d’une posologie insuffisante, va risquer de sélectionner des germes plus ou moins résistants qui pourront être plus difficiles à traiter ultérieurement quand ils se montreront pathogènes.
D’autre part, les enfants qui reçoivent souvent des antibiotiques pour des infections récidivantes finissent par sélectionner des germes.
Le problème des résistances se pose donc essentiellement dans le cadre des infections récidivantes et très peu pour l’enfant faisant une otite « par hasard ».
Pourquoi certains enfants font-ils des otites récidivantes ?
C’est une question non entièrement résolue à l’heure actuelle. L’âge et le terrain interviennent, c’est certain.
S’il est clair que les otites récidivantes sont fréquentes chez des enfants fréquentant les petites collectivités, comme les crèches, cela ne saurait représenter l’explication unique. D’ailleurs, il faut souligner et en informer les parents, que de nombreux enfants vivant en crèches ne font jamais d’otites récidivantes.
D’autres facteurs interviennent certainement, comme des déterminants génétiques, l’état général et les conditions de vie. Je remarque à ce sujet que certains enfants adoptés à l’étranger font dans un premier temps beaucoup d’otites peu après leur arrivée dans notre pays, puis n’en font plus quelques mois après.
Jusqu’à quel âge l’otite récidivante représente-elle un problème ?
En théorie jusqu’à l’âge de 2 ans, mais dans mon expérience et au vu des données des observatoires de médecine générale, il s’agit plutôt de 3 voire 4 ans ; ce qui représente une réalité relativement méconnue.
Peut-on prévenir une otite dans un contexte de récidives ?
Il faut savoir aller au-delà du simple traitement des épisodes et envisager aussi une approche préventive.
Une carence en fer peut être incriminée. Des études ont montré qu’une supplémentation martiale diminue le nombre d’otites. Des apports supplémentaires en vitamine A peuvent également être proposés chez les enfants faisant des infections ORL répétées.
Quels sont les progrès en matière d’antibiothérapie réalisés en pratique quotidienne ?
Il ne fait pas de doute que les campagnes ont développé dans le public la notion que l’antibiotique n’est pas obligatoirement la solution idéale et nous avons aujourd’hui beaucoup moins de mal qu’il y a quelques années à ne pas prescrire d’antibiotique. Les parents attendent d’abord de nous un diagnostic afin d’exclure une pathologie grave sous-jacente. Les pharmaciens peuvent nous aider à diminuer encore les pressions et à faire régresser les abus de prescriptions d’antibiotiques.
Les recommandations de 2005 de l’Afssaps ne sont entrées en application que progressivement, mais maintenant de plus en plus d’enfants de plus de 2 ans présentant une otite ne reçoivent plus d’antibiotique et guérissent sans problème en quelques jours. Une publication récente vient d’ailleurs de conforter ce que l’on savait depuis longtemps, à savoir que la plupart des otites, mêmes bactériennes, peuvent guérir sans antibiotique.
Les recommandations de 2005 sont d’instituer une antibiothérapie systématique chez les enfants entre 6 mois et 2 ans et de ne pas être systématique au-delà, mais je pense que la prochaine étape sera, comme cela est pratiqué dans de nombreux autres pays européens, de diminuer aussi l’emploi des antibiotiques pour les enfants un peu plus jeunes.
Les vaccins représentent-ils la solution définitive ?
Ils sont très utiles et il convient bien entendu d’en encourager l’emploi, mais ils ne peuvent à eux seuls résoudre le problème et un emploi plus rationnel des antibiotiques est de toute façon indispensable, notamment en évitant d’en prescrire trop vite.
En effet, si l’on considère, là encore le cas du pneumocoque, nous disposons depuis peu d’un nouveau vaccin antipneumococcique* renfermant 13 sérotypes, utilisable à partir de 2 mois selon les recommandations du calendrier vaccinal, qui remplace celui à 7 sérotypes. Mais il existe près de 70 sérotypes différents de pneumocoques ! D’autre part, son emploi risque, comme pour la première version d’ailleurs, de modifier l’épidémiologie des pneumocoques et d’induire l’émergence de certains sérotypes ; cela semble d’ailleurs être actuellement le cas avec l’émergence du sérotype 19A, qui a tendance en plus à être moins sensible à la pénicilline.

Article suivant
Quatre stratégies cosmétiques pour faire la peau au froid
Ces bactéries qui résistent (presque) à tout
Quatre stratégies cosmétiques pour faire la peau au froid
Questions de température
Faut-il recourir au spécialiste ?
Habillez votre rayon « libre accès » pour l’hiver
Antitussifs : la nouvelle donne
Grippe A(H1N1), année 2 : l’état de veille
Solutions douces pour saison froide
Toutes les armes contre les rhumes
Monsieur Éric D., 72 ans
Autour de l’ordonnance
Diabète de type 2 : recommandations actualisées pour une offre thérapeutique étoffée
Formation
L’IGAS propose de remplacer l’obligation de DPC par…
Une enquête de l’ANEPF
Formation initiale : le cursus pharmaceutique doit-il évoluer ?
Rémunération
ROSP qualité : plus que deux semaines pour s’autoévaluer !